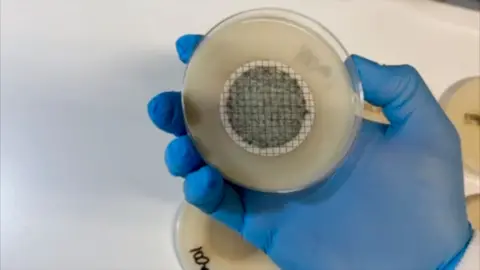
A sample showing ESBL bacteria

Antibiotic-resistant bacteria found in Oxford rivers
BBCA new study has found widespread traces of antibiotic‑resistant bacteria in Oxford's river systems, prompting calls for year‑round water sampling.
In the study, tests were carried out at four sites across the city, including the Oxford Sewage Treatment Works outfall, which is operated by Thames Water.
It found 97% of all samples tested positive for strains of bacteria, known as ESBLs, that have developed the ability to be resistant to many types of antibiotics. This makes infections more difficult to treat.
Thames Water said it was normal for treated wastewater to contain bacteria.
The research was led by Dr Rob Morley of Index Microbiology in Bristol.
He said: "This is a call to arms for regulators, researchers and utility companies alike."

He said it could potentially pose a public health risk to people who use the river for recreation.
"We've demonstrated that even a small study can uncover hidden risks. What's needed now is a full-scale, multi-agency effort to understand and address the implications," said Dr Morley.
Last year's tests, carried out in May and June, found ESBL concentration upstream much lower than downstream of the treatment works outfall, where up to 1,070 colony forming units (cfu) in 100ml of water were detected.
A secondary test carried out this month at the outfall, during a spill of untreated sewage, showed a level of 8,600cfu per 100ml.
There are no legally binding limits for ESBLs in our waterways. However if levels of E. Coli bacteria reach 1,000cfu, water is considered unsuitable for bathing.
ESBLs fall under the umbrella term of antimicrobial resistance (AMR), which develops when the microbes that cause infections evolve in such a way that many drugs no longer work.
The World Health Organisation (WHO) describes AMR as one of the most serious global health threats.
'Early warning signs'
The Oxford study was supported by the campaign groups Windrush Against Sewage Pollution (WASP), HoTWater and the Angling Trust.
Ash Smith, co-founder of WASP, said: "What we're seeing are the early warning signs of a serious and largely invisible health risk. Antibiotic resistance is a global crisis, and we're flushing it into our rivers."
Alex Farquhar, of the Angling Trust, said: "We are deeply concerned by these results.
"Not only does the river pose a risk to our members simply by sitting on the riverbank to fish, but we also have no idea of the impact of these pathogens on fish and the broader ecosystem."
A spokesman for Thames Water said: "It is part of normal sewage treatment works operations that our treated final effluent will still have bacteria in it.
"Our sewage treatment works operate to standards that are set by the Environment Agency… which don't routinely require disinfection or sterilisation."
The UK government has a national action plan for tackling antimicrobial resistance and the Environment Agency is working with the water industry on a Chemical Investigation Programme.
